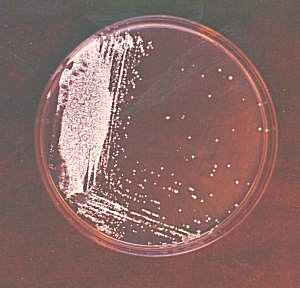

|
Various types of organisms and microorganisms live in soil. Moles, groundhogs, prarie dogs, and others of moderate size churn up the soil while making tunnels and burrows. Some microorganisms also burrow and channel through soil, which improves soil structure and aggregation, while other microorganisms have the ability to break down resistant organic matter such as lignin, toxins, and pesticides. Microorganisms also have the ability to protect plants from antagonistic pathogens and some can dissolve minerals, making nutrients available to plants.
 Earthworms are like "Nature's Tillers". They incorporate dead organic matter into soil, ingest it, and excrete the nutrient rich casts on to and in soil. Earthworms improve aeration, water infiltration, drainage, and they enhance nutrient availability and cycling. Dung Beetles and Termites also incorporate dead organic matter into soil. Earthworms are like "Nature's Tillers". They incorporate dead organic matter into soil, ingest it, and excrete the nutrient rich casts on to and in soil. Earthworms improve aeration, water infiltration, drainage, and they enhance nutrient availability and cycling. Dung Beetles and Termites also incorporate dead organic matter into soil. 
Fungi are able to break down resistant materials such as cellulose, gums, and lignin. They dominate in acidic, sandy soils and in fresh organic matter.
Actinomycetes also are able to decompose resistant substances in soil. One type, Frankia, help plants get nutrients needed from the air by breaking triple bonded nitrogen down into ammonium that plants can use. Antibiotics are made from soil Actinomycetes.
Bacteria decompose a wider range of earth material than any other microbe group. Heterotrophs gain their energy and Carbon from other organisms, while Autotrophs synthesize their own energy from light or by chemical oxidation. Some bacteria can fix nitrogen in to forms plants can use.
|